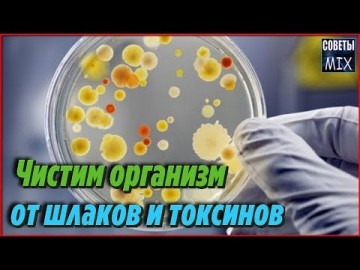
Список продуктов, которые легко помогут очистить организм от шлаков и токсинов. Советы для здоровья

Как простая овсяная вода укрепляет и омолаживает организм. Как приготовить рецепт здоровья
Овсяная вода укрепляет и омолаживает организм, регулирует обмен веществ. Буквально чувствуется, какие идут перемены. Появляется легкость в теле, бодрость, все функционирует без сбоев. Вы получите полностью натуральное и эффективное средство для поддержания организма в рабочем состоянии.
Крепкого Вам здоровья!
Новостной сайт E-News.su | E-News.pro. Используя материалы, размещайте обратную ссылку.
Оказать финансовую помощь сайту E-News.su | E-News.pro
Если заметили ошибку, выделите фрагмент текста и нажмите Ctrl+Enter (не выделяйте 1 знак)